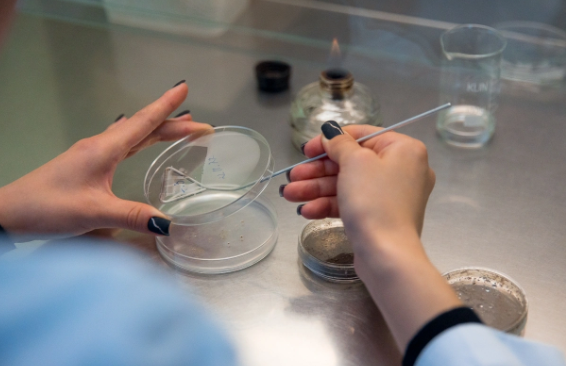

Напичкана отравой: рыбная "вкусняшка" не прошла проверку на качество в Приморье
Оба вида бактерий могут вызывать тяжелые отравления
 Самое популярное за 6 часов
Самое популярное за 6 часов

Оба вида бактерий могут вызывать тяжелые отравления
 Самое популярное за 6 часов
Самое популярное за 6 часов